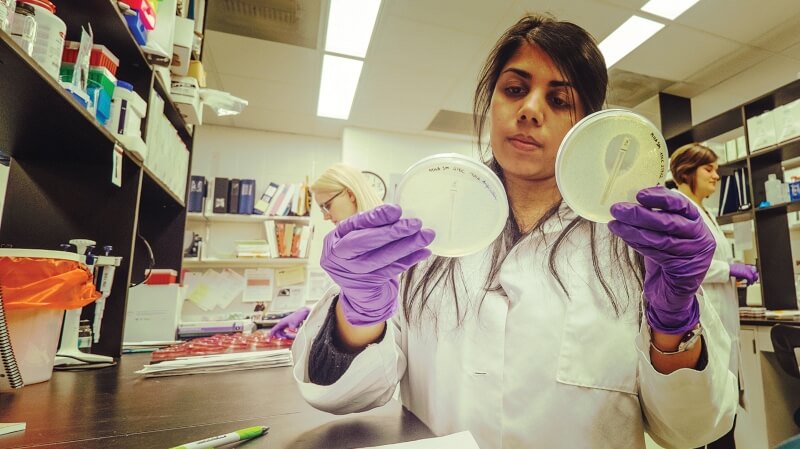
Lyman Briggs majors wearing white lab coats and gloves use lab equipment.

Lyman Briggs College is an undergraduate, residential college with 39 majors, offering students a solid foundation in biological, physical, mathematical and computational sciences while also exploring the impact of science in society.
As a residential college, Lyman Briggs provides a close-knit living-learning community for students, with small class sizes and support from faculty, staff, advisers and peers, all within the same building where students live.
Lyman Briggs has limited space, and students are encouraged to apply early for admission by listing their major as Lyman Briggs College. Students may only apply as a first-year applicant.
Biological Sciences
Environmental Sciences
Mathematical and Computational Sciences
Physical Sciences
Social Sciences
Graduates from Lyman Briggs College pursue careers in a range of industries, excelling in jobs that demand deep knowledge of the core sciences and humanities.
Visit Lyman Briggs College
More information on Lyman Briggs Majors
View courses